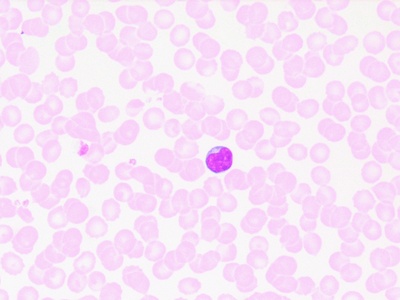
Lymphocyte
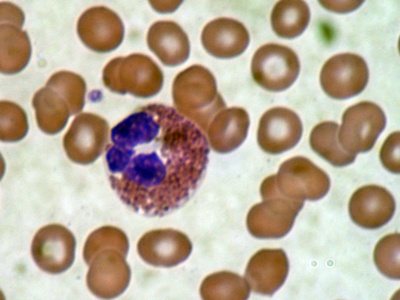
Eosinophil

From the fat storing cells in adipose tissue to tiny budding fungi under a microscope, cell types vary widely across habitats and organisms. This list brings together familiar and specialized examples from animals, plants, fungi and protists to make comparisons quick and useful for study or reference.
There are 54 Eukaryotic Cells, ranging from Adipocyte to Yeast cell (budding). For each entry you’ll find below data organized with Kingdom,Typical size (µm),Primary function so you can scan taxonomic group, approximate size and role at a glance — you’ll find below the full list and details.
How are the cell types grouped and named?
Entries use common cell names and are grouped by Kingdom; the Kingdom column shows the larger taxonomic context, Typical size (µm) gives an approximate dimension for comparison, and Primary function summarizes what the cell does, making it easy to compare across groups.
How should I interpret the Typical size (µm) values?
Treat sizes as approximate averages — cell dimensions change with state and measurement method. Use the Typical size (µm) alongside Primary function (and Kingdom) to understand why some cells are much larger or smaller, for example storage cells versus rapidly dividing yeast.
Eukaryotic Cells
| Cell type | Kingdom | Typical size (µm) | Primary function |
|---|---|---|---|
| Neuron | Animalia | 10-50 µm | Transmit electrical signals |
| Skeletal muscle cell (myocyte) | Animalia | 10-100 µm (width) | Contract to produce voluntary movement |
| Cardiomyocyte | Animalia | 10-25 µm (width) | Pump blood by contracting heart muscle |
| Smooth muscle cell | Animalia | 3-8 µm (width) | Sustain involuntary contractions in organs |
| Erythrocyte (red blood cell) | Animalia | 6-8 µm | Transport oxygen via hemoglobin |
| Neutrophil | Animalia | 10-12 µm | Engulf and destroy microbes (phagocytosis) |
| Lymphocyte | Animalia | 7-15 µm | Adaptive immune recognition and memory |
| Macrophage | Animalia | 10-30 µm | Phagocytose debris and present antigens |
| Eosinophil | Animalia | 12-17 µm | Fight parasites and modulate allergies |
| Basophil | Animalia | 10-14 µm | Release histamine in allergic responses |
| Dendritic cell | Animalia | 10-20 µm | Antigen presentation to activate T cells |
| Hepatocyte | Animalia | 20-30 µm | Metabolize nutrients and detoxify blood |
| Adipocyte | Animalia | 25-200 µm | Store energy as fat and secrete hormones |
| Osteoblast | Animalia | 20-30 µm | Form new bone matrix |
| Osteocyte | Animalia | 10-20 µm | Maintain bone tissue and sense strain |
| Osteoclast | Animalia | 30-100 µm | Resorb bone during remodeling |
| Chondrocyte | Animalia | 10-20 µm | Produce and maintain cartilage matrix |
| Keratinocyte | Animalia | 10-50 µm | Form protective skin barrier |
| Melanocyte | Animalia | 10-15 µm | Produce pigment melanin to protect skin |
| Goblet cell | Animalia | 10-20 µm | Secrete mucus to protect and lubricate surfaces |
| Pancreatic beta cell | Animalia | 10-20 µm | Secrete insulin to regulate blood glucose |
| Spermatozoon (sperm cell) | Animalia | 5-60 µm (total length) | Deliver paternal DNA to oocyte for fertilization |
| Oocyte (egg cell) | Animalia | 100-150 µm | Provide maternal nucleus and resources for embryo |
| Hematopoietic stem cell | Animalia | 10-15 µm | Generate blood cell lineages throughout life |
| Enterocyte | Animalia | 15-20 µm | Absorb nutrients in the small intestine |
| Podocyte | Animalia | 20-40 µm | Filter blood in kidney glomerulus |
| Olfactory receptor neuron | Animalia | 10-20 µm | Detect airborne odorants and relay signals |
| Rod photoreceptor | Animalia | 10-50 µm (length) | Detect low-light visual signals |
| Cone photoreceptor | Animalia | 10-50 µm (length) | Detect color and fine spatial detail |
| Hair cell (auditory) | Animalia | 10-15 µm | Convert sound vibrations to neural signals |
| Choanocyte (collar cell) | Animalia | 5-10 µm | Capture food particles and drive water flow in sponges |
| Cnidocyte | Animalia | 20-50 µm | Sting and capture prey using nematocysts |
| Parenchyma cell | Plantae | 10-100 µm | Photosynthesis, storage and regeneration in plants |
| Guard cell | Plantae | 20-40 µm | Open and close stomata to regulate gas exchange |
| Xylem vessel element | Plantae | 200-2,000 µm (length) | Transport water and minerals upward in plants |
| Phloem sieve-tube element | Plantae | 100-1,500 µm (length) | Transport sugars and signaling molecules |
| Sclerenchyma fiber | Plantae | 100-2,000 µm (length) | Provide rigid support and protection in plants |
| Root hair cell | Plantae | 100-1,000 µm (length) | Increase root surface area for water absorption |
| Tracheid | Plantae | 200-4,000 µm (length) | Conduct water and support xylem structure |
| Mesophyll cell | Plantae | 20-50 µm | Capture light for photosynthesis in leaves |
| Meristematic cell | Plantae | 5-20 µm | Divide to produce new plant tissues and organs |
| Hyphal cell | Fungi | 5-10 µm (diameter) | Absorb nutrients and extend fungal mycelium |
| Yeast cell (budding) | Fungi | 3-8 µm | Asexual reproduction and fermentation metabolism |
| Basidium | Fungi | 10-20 µm | Produce basidiospores during sexual reproduction |
| Ascus | Fungi | 20-50 µm | Enclose and release ascospores after meiosis |
| Ascospore | Fungi | 5-20 µm | Disperse and germinate to form new fungal growth |
| Basidiospore | Fungi | 5-15 µm | Disperse to establish new fungal individuals |
| Ciliate cell | Protista | 50-300 µm | Move and feed using cilia coordination |
| Flagellate protist cell | Protista | 10-100 µm | Swim using one or more flagella |
| Amoeboid cell | Protista | 10-500 µm | Move and phagocytose using pseudopodia |
| Dinoflagellate cell | Protista | 20-200 µm | Photosynthesize and sometimes cause bioluminescence |
| Diatom cell | Protista | 2-200 µm | Photosynthetic primary producers with silica shells |
| Foraminiferan cell | Protista | 100-1,000 µm | Build external shells and capture food |
| Hemocyte (invertebrate) | Animalia | 5-20 µm | Immune defense and wound repair in invertebrates |
Images and Descriptions

Neuron
Neurons are nerve cells in animals that carry electrical and chemical messages. They have dendrites, a cell body and often a long axon. Notable for synapses and long-range signaling, they enable sensation, movement and cognition.

Skeletal muscle cell (myocyte)
Skeletal muscle cells are long, multinucleated fibers that attach to bones. They contract via organized actin and myosin filaments and are specialized for powerful, voluntary movements and endurance, often forming long syncytial cells.

Cardiomyocyte
Cardiomyocytes are heart muscle cells with branched structures and intercalated discs for electrical coupling. They contract rhythmically to pump blood and display abundant mitochondria for continuous energy. Found only in vertebrate hearts.

Smooth muscle cell
Smooth muscle cells are spindle-shaped, non-striated cells lining organs and blood vessels. They contract slowly to regulate blood flow, gut motility and organ tone and respond to autonomic and local signals.

Erythrocyte (red blood cell)
Erythrocytes are oxygen-carrying blood cells in vertebrates; mature mammalian erythrocytes lack a nucleus. Their biconcave shape increases surface area for gas exchange, enabling efficient oxygen transport to tissues.

Neutrophil
Neutrophils are fast-responding white blood cells that ingest and kill bacteria. They circulate in blood and move into tissues during infection, releasing antimicrobial enzymes and forming pus at infection sites.
Lymphocyte
Lymphocytes are immune cells including B and T cells that recognise specific antigens. Found in blood, lymph and lymphoid organs, they mount targeted immune responses and retain memory of past infections.

Macrophage
Macrophages are large tissue immune cells that ingest pathogens and dead cells, secrete signaling molecules, and present antigens to lymphocytes. They occur in nearly all tissues and are vital for innate immunity and repair.
Eosinophil
Eosinophils are granulocytic white blood cells involved in parasitic defense and allergic inflammation. They release toxic granules and signaling molecules and are commonly elevated in allergic conditions and helminth infections.

Basophil
Basophils are rare blood leukocytes that contain histamine-rich granules. They participate in allergic reactions and inflammatory responses by releasing mediators that widen blood vessels and recruit other immune cells.

Dendritic cell
Dendritic cells are professional antigen-presenting immune cells found in tissues and lymphoid organs. They capture antigens, migrate to lymph nodes, and activate adaptive immune responses by priming T cells.

Hepatocyte
Hepatocytes are the main functional cells of the liver, performing detoxification, protein synthesis, and metabolism of carbohydrates and lipids. They line hepatic plates and have abundant smooth and rough endoplasmic reticulum.

Adipocyte
Adipocytes are fat-storing cells in adipose tissue; sizes vary widely. They store triglycerides, insulate and cushion organs, and release hormones like leptin that regulate appetite and metabolism.

Osteoblast
Osteoblasts are bone-forming cells that secrete collagen and minerals to build bone. They line bone surfaces, eventually become embedded as osteocytes, and are essential for growth, remodeling and repair.

Osteocyte
Osteocytes are mature bone cells embedded in mineralized matrix with long dendritic processes. They maintain bone homeostasis, sense mechanical stress, and coordinate remodeling by signaling to osteoblasts and osteoclasts.

Osteoclast
Osteoclasts are large, multinucleated cells that break down bone by secreting acids and enzymes. They balance bone formation by removing old or damaged matrix during growth, repair and calcium regulation.

Chondrocyte
Chondrocytes are cartilage-producing cells embedded in a dense extracellular matrix rich in collagen and proteoglycans. They provide flexible support in joints, the nose and other structures, and have limited regenerative capacity.

Keratinocyte
Keratinocytes are the predominant epidermal cells that produce keratin protein and form layers of skin. They create a waterproof barrier against pathogens and abrasion and undergo programmed differentiation toward the surface.

Melanocyte
Melanocytes are pigment-producing cells in skin and hair follicles that synthesize melanin within melanosomes. They transfer pigment to keratinocytes, contributing to coloration and protecting DNA from UV damage.

Goblet cell
Goblet cells are mucus-secreting epithelial cells lining respiratory and intestinal tracts. Their cup-like shape stores mucin granules that are released to trap particles, moisten surfaces, and aid passage of material.

Pancreatic beta cell
Beta cells are endocrine cells in pancreatic islets that detect blood glucose and release insulin. They play a central role in metabolic homeostasis and are critical in diabetes research and therapy.

Spermatozoon (sperm cell)
Sperm cells are highly specialized male gametes with compact heads and motile tails. Designed for mobility and fertilization, human sperm are about 50-60 µm long and carry paternal genetic material.

Oocyte (egg cell)
Oocytes are large female gametes containing cytoplasm rich in nutrients and organelles. They are among the biggest single cells in animals, enabling early embryo development after fertilization.

Hematopoietic stem cell
Hematopoietic stem cells reside in bone marrow and self-renew while producing red, white and platelet lineages. They maintain lifelong blood production and are used in bone marrow transplants.

Enterocyte
Enterocytes are intestinal epithelial cells with microvilli forming the brush border. They absorb nutrients, electrolytes and water, and host enzymes for digestion while forming a selective barrier against pathogens.

Podocyte
Podocytes are specialized cells wrapping kidney glomerular capillaries with foot processes that create filtration slits. They play a key role in selective blood filtration and maintaining kidney filtration barrier integrity.

Olfactory receptor neuron
Olfactory receptor neurons are sensory cells in the nasal epithelium that express odorant receptors and send axons to the olfactory bulb. They enable smell detection and continual regeneration in many animals.

Rod photoreceptor
Rod cells are retinal photoreceptors specialized for dim-light vision. They contain stacked membranous discs rich in photopigment rhodopsin and provide high sensitivity but limited color discrimination.

Cone photoreceptor
Cone cells are retinal photoreceptors responsible for color vision and high-resolution sight. Different cone types contain distinct photopigments tuned to wavelengths of light and function best in bright conditions.

Hair cell (auditory)
Hair cells in the inner ear are mechanosensory cells with stereocilia that transduce mechanical vibrations into electrical signals. They are essential for hearing and balance and are vulnerable to damage.

Choanocyte (collar cell)
Choanocytes are flagellated feeding cells lining sponge chambers. Their beating flagella create water currents and capture bacteria and organic matter with a characteristic collar of microvilli.

Cnidocyte
Cnidocytes are specialized stinging cells unique to cnidarians (jellyfish, corals). Each contains a nematocyst capsule that explosively ejects a harpoon-like structure to immobilize prey or deter predators.

Parenchyma cell
Parenchyma cells are versatile plant cells found in leaves, stems and roots. They perform photosynthesis, store nutrients, and aid wound healing and regeneration due to their thin walls and metabolic activity.

Guard cell
Guard cells flank stomatal pores on leaf surfaces and change shape by altering turgor pressure. They control transpiration and CO2 intake, balancing water loss with photosynthetic needs.

Xylem vessel element
Vessel elements are elongated, hollow plant cells forming continuous tubes in xylem for efficient water transport. They die at maturity, leaving reinforced cell walls that resist collapse under tension.

Phloem sieve-tube element
Sieve-tube elements are elongated, enucleate phloem cells that transport photosynthates. Supported by companion cells, they form long conduits for distributing sugars and signals throughout the plant.

Sclerenchyma fiber
Sclerenchyma fibers are elongated plant cells with thick, lignified walls that provide structural support. Often dead at maturity, they reinforce tissues such as stems, seed coats and vascular bundles.

Root hair cell
Root hair cells are tubular extensions of root epidermal cells that dramatically increase surface area for water and nutrient uptake. They are short-lived but highly effective at soil contact and absorption.

Tracheid
Tracheids are elongated water-conducting cells in xylem with tapered ends and pit pairs for lateral water movement. Present in many vascular plants, they combine support with transport capacity.

Mesophyll cell
Mesophyll cells are photosynthetic cells within leaf tissue, including palisade and spongy types. Rich in chloroplasts, they convert light into chemical energy and facilitate gas exchange for photosynthesis.

Meristematic cell
Meristematic cells are undifferentiated, actively dividing plant cells at root and shoot tips. They generate all primary tissues, enabling growth, organ formation and the plant’s capacity to regenerate.

Hyphal cell
Hyphal cells form the thread-like filaments of fungal mycelium, growing at tips and secreting enzymes to digest substrates externally. They enable nutrient absorption and can fuse to form networks across substrates.

Yeast cell (budding)
Budding yeast cells are unicellular fungi that reproduce by budding. They metabolize sugars anaerobically or aerobically, are key in fermentation, and serve as model organisms in cell biology research.

Basidium
Basidia are specialized reproductive fungal cells in Basidiomycota that undergo meiosis to form basidiospores on external projections. They are central to mushroom and shelf fungus spore dispersal.

Ascus
An ascus is a sac-like cell in Ascomycota fungi where meiosis produces ascospores. Asci are often clustered in fruiting bodies and enable dispersal of genetically varied spores.

Ascospore
Ascospores are sexual spores produced inside asci by ascomycete fungi. They resist harsh conditions and germinate to form new hyphae, contributing to fungal life cycles and genetic diversity.

Basidiospore
Basidiospores are haploid spores released from basidia on mushrooms and related fungi. Carried by wind or animals, they germinate into hyphae that form new mycelial networks.

Ciliate cell
Ciliate cells are protists covered with coordinated cilia used for locomotion and feeding. Many are freshwater or marine predators (e.g., Paramecium), with complex organelles like micronuclei and contractile vacuoles.

Flagellate protist cell
Flagellate protists (e.g., Euglena) use flagella for propulsion and often mix autotrophy and heterotrophy. They vary greatly in shape and can be free-living or symbiotic in aquatic environments.

Amoeboid cell
Amoeboid cells use dynamic pseudopodia to crawl and engulf food particles by phagocytosis. Found in many protists and some immune cells, they adapt shape fluidly and can occupy diverse habitats.

Dinoflagellate cell
Dinoflagellates are mostly marine protists with two flagella and complex cell coverings. Many are photosynthetic plankton responsible for primary production and sometimes harmful algal blooms.

Diatom cell
Diatom cells are single-celled algae with ornate silica frustules. They perform substantial oceanic photosynthesis, form sedimentary deposits (diatomaceous earth), and show diverse, beautiful microscopic shapes.

Foraminiferan cell
Foraminifera are protists that often build calcium carbonate shells and extend reticulopodia to capture prey. Their fossilized shells are important in paleoenvironmental studies and sediment formation.

Hemocyte (invertebrate)
Hemocytes are circulating immune cells in many invertebrates that phagocytose pathogens, help clot wounds, and contribute to nutrient transport. Types vary widely across arthropods and mollusks.









